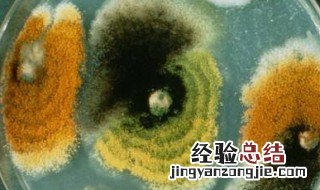

1、钠离子以被动转运方式、主动转运方式或者是易化扩散方式进入细胞,主动转运是一种特殊转运过程 , 在转运过程中除了需要有载体或运载系统参与外,可以逆浓度梯度进行转运 。
【钠离子以什么方式进入细胞 钠离子以什么方式进入细胞膜】
2、钠离子是由钠原子失去最外层的一个电子得到的 , 显正1价,钠是一种质地软、轻、蜡状而极有伸展性的银白色的IA族的碱金属元素 。
经验总结扩展阅读
-
-
-
婚房|婚房价值300多万,女子不让大哥住家里,众人逼问下艰难说出原因
-
01引言爱情 爱情,是入骨的相思;爱情,是深入灵魂的欢喜
-
-
恋爱|一个女人的层次越低,越是喜欢这两种男人,少有例外
-
2023年8月28日挖坟墓好吗 2023年农历七月十三宜挖坟墓吗
-
-
2023年农历八月廿七疏通管道吉日 2023年10月11日疏通管道吉日一览表
-
前段时间蒋丽的母亲去世了|儿媳逛街回家,看到丈夫正在给儿子做荷包蛋,发现母亲去世真相
-
2023年6月11日适合开业做生意吗 2023年6月11日开业怎么样
-
-
-
化妆品科普 | 莫让美容变毁容 三招识别变质化妆品
-
-
2024年六月初十出生赖姓女孩名字叫什么好名字推荐
-
我们年轻的时候 容纳世人遇见事情,学会宽容,方能体现大格局
-
婚姻好不好,从来都不是靠付出,无脑输出就是最大的傻子
-
苏庸子|心理学,长期单身的男人,身上这些“特征”很明显
-